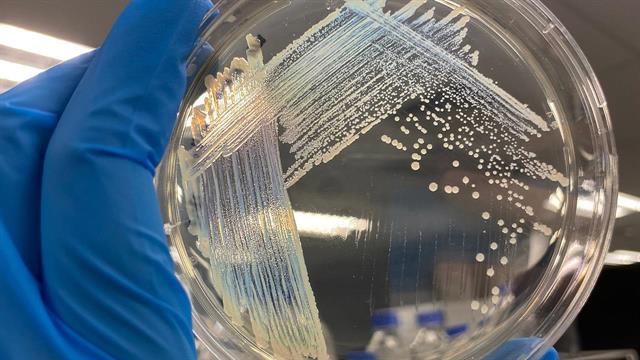
Συναγερμός στην Ευρώπη από ανθεκτικά εντεροβακτήρια - Απειλή για νοσηλευόμενους

Μεγάλη αύξηση της επίπτωσης ανθεκτικών στα αντιβιοτικά εντεροβακτηρίων σε ευρωπαϊκά νοσοκομεία, καταγράφουν οι επιστήμονες του Ευρωπαϊκού Κέντρου Ελέγχου Νοσημάτων (ECDC).
Σε σημερινή έκθεση επισημαίνεται πως η κατάσταση έχει επιδεινωθεί σημαντικά από το 2019 έως το 2023, με την τάση να είναι επιδεινούμενη στις περισσότερες χώρες.
Μεταξύ αυτών περιλαμβάνεται και η Ελλάδα, με αύξηση της αντοχής κατά 64,3% το επίμαχο διάστημα.
Οι συντάκτες της έκθεσης αναφέρουν πως προηγήθηκε μία σειρά από ενδείξεις πως η κατάσταση επιδεινώνεται. Μεταξύ αυτών περιλαμβάνεται:
- Η αύξηση της συχνότητας των λοιμώξεων ανθεκτικού στο αντιβιοτικό καρβαπενέμη της Klebsiella pneumoniae σε 23 χώρες της ΕΕ, λόγω της συνεχιζόμενης μετάδοσης σε νοσοκομεία.
- Σύγκλιση της λοιμογόνου δράσης και της αντοχής στο K. pneumoniae, συμπεριλαμβανομένης της εξάπλωσης που σχετίζεται με την υγειονομική περίθαλψη των υπερμολυσματικών γονιδίων καρβαπενεμάσης ST23.
- Νεοεμφανιζόμενα είδη εντροβακτηρίων που φέρουν γονίδια καρβαπενεμάσης.
- Διαμεσολαβούμενη από πλασμίδιο εξάπλωση των γονιδίων καρβαπενεμάσης που προκαλούν κρούσματα στα νοσοκομεία και στα δίκτυα υγειονομικής περίθαλψης.
- Αυξανόμενη ανίχνευση απομονώσεων (συμπεριλαμβανομένων μεμονωμένων περιπτώσεων και συστάδων) γονιδίων καρβαπενεμάσης υψηλού κινδύνου E. coli που φέρουν γονίδια καρβαπενεμάσης και κίνδυνος διασποράς στην κοινότητα.
Εκτίμηση κινδύνου
Με βάση την επιδείνωση της επιδημιολογικής κατάστασης, η πιθανότητα περαιτέρω εξάπλωσης των ανθεκτικων βακτηρίων είναι υψηλή.
Οι λοιμώξεις που προκαλούν συνδέονται με υψηλό ποσοστό θνησιμότητας, κυρίως λόγω καθυστέρησης στη χορήγηση αποτελεσματικής αντιμικροβιακής θεραπείας και του περιορισμένου αριθμού εναλλακτικών θεραπευτικών επιλογών.
Η συνεπής εφαρμογή μέτρων πρόληψης και ελέγχου των λοιμώξεων μπορεί να μειώσει την εξάπλωσή τους, αλλά η εφαρμογή τους σε πολλά νοσοκομεία δεν είναι η βέλτιστη.
Εάν η εξάπλωσή τους συνεχιστεί με τον τρέχοντα ρυθμό, ο αντίκτυπος αναμένεται να είναι υψηλός.
Προσθέστε το iatronet.gr στο DiscoverΕιδήσεις υγείας σήμερα
Ποιες τροφές καταπολεμούν το στρες
Η Κύμη τίμησε την παρακαταθήκη του Γεωργίου Παπανικολάου με μια εκδήλωση για την υγεία
Οι υπερεπεξεργασμένες τροφές συνδέονται με διαφορές στον εγκέφαλο παιδιών [μελέτη]
ECDC: Μεγάλη ανησυχία από γονιδιακή αλλαγή σε κλεμπσιέλλα - Τι ισχύει με το gram-αρνητικό βακτήριο E. coli
ECDC: Μεγάλη ανησυχία από γονιδιακή αλλαγή σε κλεμπσιέλλα - Τι ισχύει με το gram-αρνητικό βακτήριο E. coli Μικροβιακή αντοχή: Μία πανδημία σε αργή κίνηση που μπορούμε να αποτρέψουμε
Μικροβιακή αντοχή: Μία πανδημία σε αργή κίνηση που μπορούμε να αποτρέψουμε Η ΕΕ επενδύει 30 εκατομμύρια ευρώ για την καταπολέμηση της μικροβιακής αντοχής
Η ΕΕ επενδύει 30 εκατομμύρια ευρώ για την καταπολέμηση της μικροβιακής αντοχής ECDC: Υψηλή μικροβιακή αντοχή σε ανθρώπους και ζώα στην Ελλάδα
ECDC: Υψηλή μικροβιακή αντοχή σε ανθρώπους και ζώα στην Ελλάδα Μικροβιακή αντοχή: Ο ΠΟΥ καλεί σε αντίδραση
Μικροβιακή αντοχή: Ο ΠΟΥ καλεί σε αντίδραση Η Σερβία καλεί το CLEO για την εκπόνηση Εθνικού Σχεδίου Δράσης κατά της Μικροβιακής Αντοχής
Η Σερβία καλεί το CLEO για την εκπόνηση Εθνικού Σχεδίου Δράσης κατά της Μικροβιακής Αντοχής Ποιες τροφές καταπολεμούν το στρες
Ποιες τροφές καταπολεμούν το στρες Ψυχοθεραπεία μέσω εικονικής πραγματικότητας - Πώς εφαρμόζεται
Ψυχοθεραπεία μέσω εικονικής πραγματικότητας - Πώς εφαρμόζεται Καλοκαίρι και θηλασμός: Στις διακοπές γίνεται ακόμη πιο πολύτιμος
Καλοκαίρι και θηλασμός: Στις διακοπές γίνεται ακόμη πιο πολύτιμος "Προλαμβάνω" - Παχυσαρκία: Προβλήματα σε ασθενείς από την ολοκλήρωση του προγράμματος
"Προλαμβάνω" - Παχυσαρκία: Προβλήματα σε ασθενείς από την ολοκλήρωση του προγράμματος Στατίνες: Προκαλούν σοβαρά μυϊκά προβλήματα;
Στατίνες: Προκαλούν σοβαρά μυϊκά προβλήματα; Τι ζητούν οι Τεχνολόγοι Ιατρικών Εργαστηρίων
Τι ζητούν οι Τεχνολόγοι Ιατρικών Εργαστηρίων Ανακαλείται επιδόρπιο γάλακτος πουτίγκας με γεύση σοκολάτα
Ανακαλείται επιδόρπιο γάλακτος πουτίγκας με γεύση σοκολάτα Ιδέες για πρωινό με πολλή πρωτεΐνη
Ιδέες για πρωινό με πολλή πρωτεΐνη Ρύζι, πατάτες και ζυμαρικά: Ποιο είναι χειρότερο για το σάκχαρο;
Ρύζι, πατάτες και ζυμαρικά: Ποιο είναι χειρότερο για το σάκχαρο; Aνατροπή της τελευταίας στιγμής
Aνατροπή της τελευταίας στιγμής Pfizer: Νέα ιατρική διευθύντρια η Χριστίνα Μιχαηλίδη
Pfizer: Νέα ιατρική διευθύντρια η Χριστίνα Μιχαηλίδη Τι πιστεύουν οι υγειονομικοί για τον αντιγριπικό εμβολιασμό [έρευνα]
Τι πιστεύουν οι υγειονομικοί για τον αντιγριπικό εμβολιασμό [έρευνα]